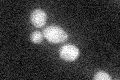
YPR176C
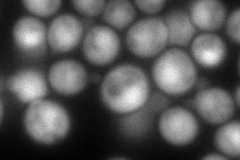
YPR176C
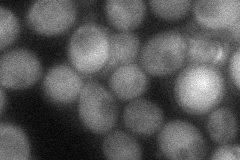
YPR176C
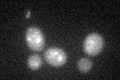
YPR176C

View description
Beta subunit of Type II geranylgeranyltransferase required for vesicular transport between the endoplasmic reticulum and the Golgi; provides a membrane attachment moiety to Rab-like proteins Ypt1p and Sec4p
Localization:
Intensity:
Fold change:
Significance:
-
C’ GFP library in SD
below threshold17.77 -
N' NOP1pr-GFP in SD

cytosol,nucleus152.827 -
N' TEF2pr-mCherry in SD
cytosol,nucleus132.547 -
N' NATIVEpr-GFP in SD

cytosol37.7533 -
N' TEF2pr-VC and Cyto-VN in SD
cytosol43.0788 -
C’ GFP library in SD+DTT
cytosol17.440.98No -
C’ GFP library in SD+H2O2

cytosol16.160.9No -
C’ GFP library in Starvation Media

cytosol21.251.19No -
C’ GFP library on the background of Pup2-DaMP

below threshold -
C’ GFP library on the background of CCT mutant

below threshold17.65260.993083No
